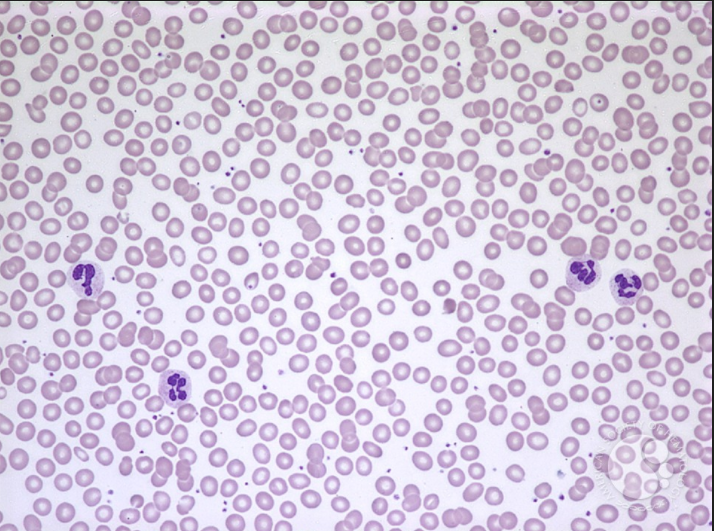

T/F: All preganglionic fibers whether sympathetic or parasympathetic release acetylcholine
TRUE
CD55 is a marker that is present on ____, ____________, and _______ and prevents complement-mediated destruction of these cells.
CD55 is a marker that is present on RBCs, white blood cells, and platelets and prevents complement-mediated destruction of these cells.
a well known side effect of ACE inhibitors is edema/swelling. This is caused by ..?
ACE inhibitors are generally prescribed to patients with hypertension. Angioedema is caused by the secondary activity of ACE on the degradation of kinins, including, most commonly, bradykinin. The blockage of ACE, and the commensurate accumulation of high levels of bradykinin, account for increased vessel permeability and subsequent edema in the face, lips, mouth, and subglottic tissues (which causes respiratory distress), typically without pruritus
This patient presents with a complaint of dark-colored urine in the morning that resolves as the day progresses and fatigue and abdominal pain. Her laboratory results show that she is experiencing normocytic anemia. Additionally, flow cytometry showed her RBCs were negative for CD55/59. What is the most likely diagnosis.
paroxysmal nocturnal hemoglobinuria (PNH). PNH results from an abnormality in the PIG-A gene, which normally helps produce glycophosphatidylinositol (GPI) anchors. Many proteins use GPI anchors to attach to the extracellular surface of cells. Two of these proteins are CD59 (also called membrane attack complex inhibitory factor) and CD55 (decay accelerating factor). These two proteins are necessary to prevent host cells from being lysed by nonspecific activation of the complement pathway.
what abx is indicated for suspected methicillin sensitive staphylococcus aurus infection
*methicillin is not used anymore due to renal toxicity

which abx are indicated for critically ill patients with infection of:
a gram positive cocci, gram neg rod, pseudomona infection (or, MSSA, strep)

what is a granuloma and how does it form (including what factors)
granulomas are a subtype of chronic inflammation. the body attemps to contain a substance that it perceives as foreign but is unable to eliminate. formation is mediated by interferon-γ release from Th1 cells which activate macrophages

what infection are these images most consistent with?

myoconium TB
risk factors:
describe the process (including names of receptors, factors, etc) of neutrophil recruitment into a tissue

LFA-1 is a(n) ___________ located on surface of __________
It interacts with ______ or ______ on the surface of __________ or ___________
LFA-1 is a(n) integrin located on surface of T-cells
It interacts with neutrophils or T cells on the surface of endothelium (in extravasation) or APC

P-selectin vs E-selectin vs L-selectin
Selectins are a family of three closely related glycoproteins (P-selectin expressed on platelets and leukocytes,
E-selectin expressed on endothelial cells, and
L-selectin expressed on leukocytes, monocytes, neutrophils, and eosinophils).
Is this a normal or abnormal peripheral blood smear
normal (nmp # of leukocytes)
T/F: Neutropenia is most commonly a result of drug toxicity
TRUE
what is the structure of a microvilli

what is the structure of cilia

what are interdigitating cytoplasmic projections?

what is the structure pointed to

basement membrane (of epithelial tissue)
functions:
separation
filtration
cell signaling
structure
T/F; cells within an epithelial tissue all have the same function
False e.g. goblet cells secrete
what is each region referring to?

the 3 types of junctional complexes (they virtually always go in this order)
ZO=zona occludens - very closely associatead lateral membranes joined together via tight junctions virtually impermeable to fluids
ZA= Zona adherens: ribbon like structures of cadherins that transmit contractile forces. On the intracellular side, they are bound to actin filaments
MA= Macula Adherens: attachment via desmosomes (patchlike structures specialized for cell-cell adhesion). On intracellular side they are bound to intermediate filamnets
what does the RER look like under electon microscopy

what is the function of the organelle being pointed to (red arrow)

It’s the SER because no bumps, so the functions are
what type of connective tissue?

loose
what type of connective tissue?

dense regular connective tissue
what kind of connective tissue?

dense irregular CT